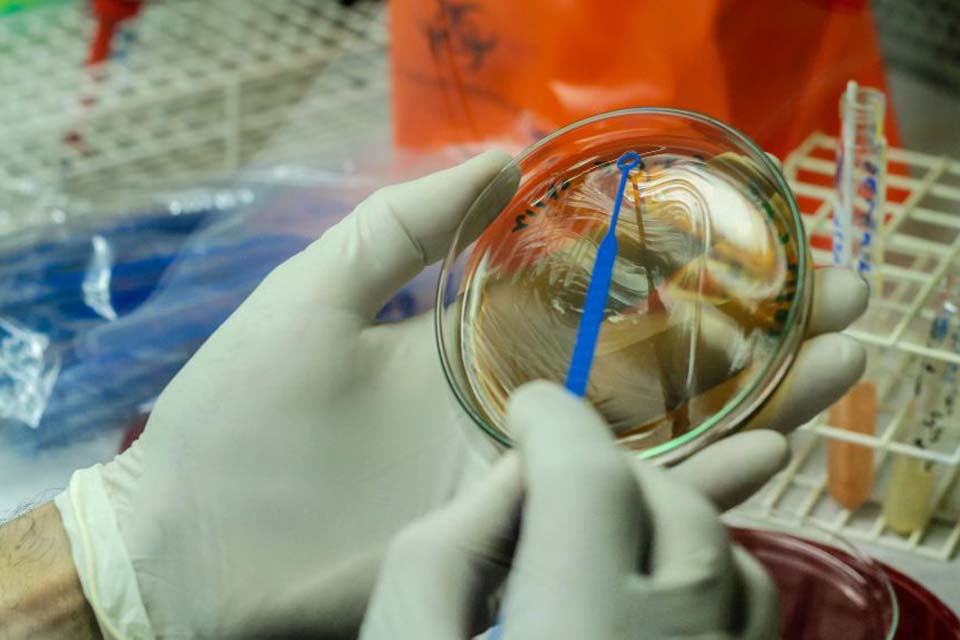
Casos suspeitos de Monkeypox em Rondônia são descartados; resultado é emitido por laboratório referência

Publicada em 13/06/2022 às 12h54
Neste domingo (12), os dois casos suspeitos de Monkeypox vírus, no município de Rio Crespo, foram descartados após liberação do resultado não reagente do Laboratório de Saúde Pública da Fundação Ezequiel Dias – Funed, com sede em Minas Gerais, referência para as regiões Norte e Nordeste dos casos suspeitos do vírus.
A informação acerca da classificação dos casos como descartados foi encaminhada pelo grupo de trabalho, formado por equipe multidisciplinar da Agência Estadual de Vigilância em Saúde no Estado de Rondônia – Agevisa.
As duas amostras foram enviadas para análise ao Laboratório Central de Saúde Pública de Rondônia – Lacen. Uma das amostras foi enviada para a Funed para detecção do vírus e a outra ficou no Lacen para diagnóstico diferenciado que possibilita a detecção de outras doenças. “Na sexta-feira (10) a amostra chegou ao Funed e neste domingo (12), fomos informados oficialmente que os casos investigados não são da doença Monkeypox, sendo descartados pela referência nacional”, informou o diretor-geral da Agevisa, Gilvader Gregório de Lima.
Ainda na tarde de domingo, a Sala de Situação da Monkeypox no Ministério da Saúde, por meio do Informe N° 21 retirou da lista de casos suspeitos, os notificados em Rondônia, que segundo a definição foram descartados por diagnóstico laboratorial.
VIGILÂNCIA
A Gerência Técnica de Vigilância Epidemiológica e o Centro de Informações Estratégicas de Vigilância em Saúde – CIEVS/Agevisa estavam monitorando diariamente os casos.
Um alerta epidemiológico foi emitido para todo o Estado, ficando todas as vigilâncias epidemiológicas (Estado, regional e municípios) em atenção para a detecção, notificação e investigação imediata de quaisquer casos suspeitos.
Segundo fluxo estadual os casos devem ser comunicados ao CIEVS, pelos números 0800-642-5398/69 8459-1610 e/ou pelo endereço de e-mail: [email protected]
MONKEYPOX
Para evitar que haja um estigma e ações contra os Primatas Não Humanos – PNH do gênero macaco, optou-se por não denominar a doença no Brasil como varíola dos macacos, pois embora tenha se originado em animais desse gênero, o surto atual não tem relação com ele.
Apesar do estrangeirismo, uma tentativa de solucionar a situação foi a de usar a denominação indicada pela Organização Mundial de Saúde – OMS, de “Monkeypox”; com o intuito de se evitar desvio dos focos de vigilância e ações contra os animais.
 imprimir
imprimir














